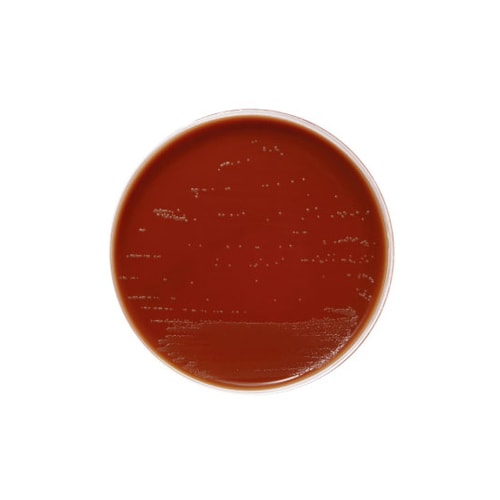
【冷蔵】256271チョコレートII寒天培地20枚

日本ベクトン・ディッキンソン
BD BBL(TM) バシトラシン添加チョコレート2寒天培地 20枚 256271 培地 その他 1個(20枚)
【3167-7615】



| ¥8,485 (税込) / ¥7,714 (税抜) |
| ¥8,485 (税込) / ¥7,714 (税抜) |
| メーカー希望小売価格※税抜 (割引率) ¥8,120(5%) |
|---|
培地関連用品の売れ筋ランキング
- ¥3,135(税込) (税込) 〜
- ¥7,524(税込) (税込) 〜
- ¥11,547(税込) (税込) 〜
- ¥6,030(税込) (税込)
商品の特徴 |
バシトラシン添加チョコレートII寒天培地は、チョコレートII寒天培地〔GCII寒天培地を基礎としてヘモグロビンとエンリッチメント(アイソバイタルX)を加えた培地〕にバシトラシンを添加した培地です。常在菌が存在する上気道の検体からHaemophilusを選択的に分離し、すぐれた発育を期待することができます |
|---|---|
商品仕様 |
|
メーカー情報 |
|
カタログ掲載ページ |
-/- |
| 注意事項 | ※この商品は貯蔵または配送の際に冷蔵が必要な商品です。 |
|---|